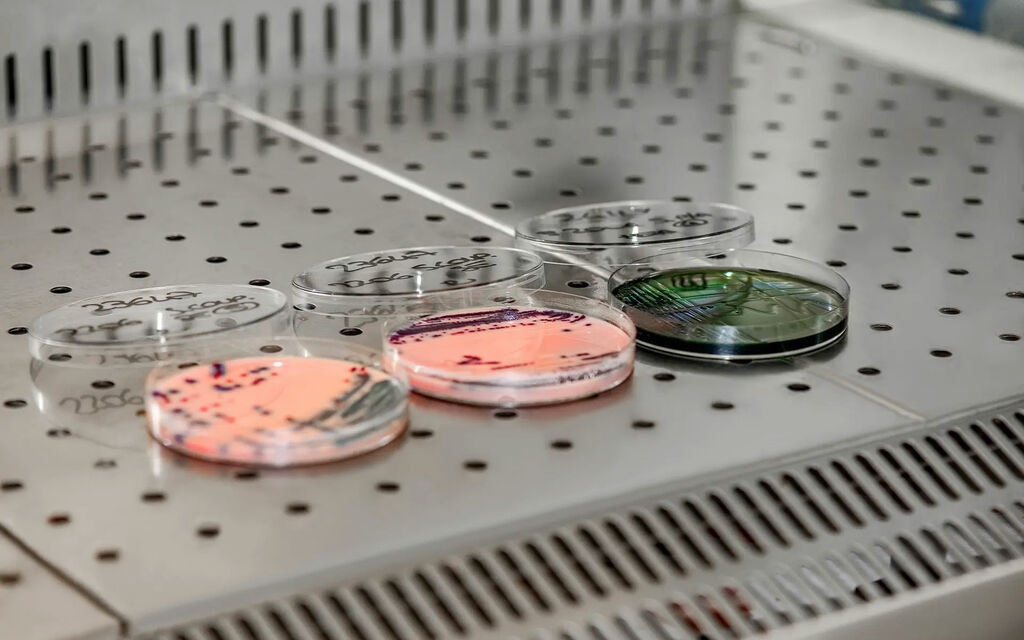
Batteri Ristoranti E4db1

Controlli in ristoranti, 1 su 4 problematico
Poco meno di un quarto dei controlli batteriologici effettuati in ristoranti dei Cantoni Grigioni e Glarona lo scorso anno sono risultati problematici. Il quadro complessivo è solo lievemente migliore del 2022, indica un comunicato diramato dall'Ufficio grigionese per la sicurezza delle derrate alimentari e la salute degli animali.
«I frequenti cambi di gestione e la carenza di manodopera qualificata rendono difficile migliorare significativamente la situazione generale», scrivono le autorità retiche.
Nei due cantoni sono registrati circa tremila esercizi attivi nella ristorazione, prima di tutto ristoranti, ma anche mense, cucine di ospedali e servizi di catering. In 258 di essi tra gennaio e dicembre sono stati effettuati 1022 campionamenti: il 22,6% (anno precedente: 25,0%) non ha soddisfatto i requisiti in ambito microbiologico.
Tasso elevato di recidiva, male test inopinati
In 30 esercizi che in un primo controllo hanno fornito "risultati molto insoddisfacenti" ne è stato eseguito un secondo: su 91 campioni, il 36,3% (anno precedente: 36,6%) non rispettava le norme.
Le competenti autorità hanno anche proceduto senza preavviso a 26 campionamenti in undici stabilimenti: il 26,9% (anno precedente: 35,3%) è risultato non conforme alle regole.
Articoli correlati






